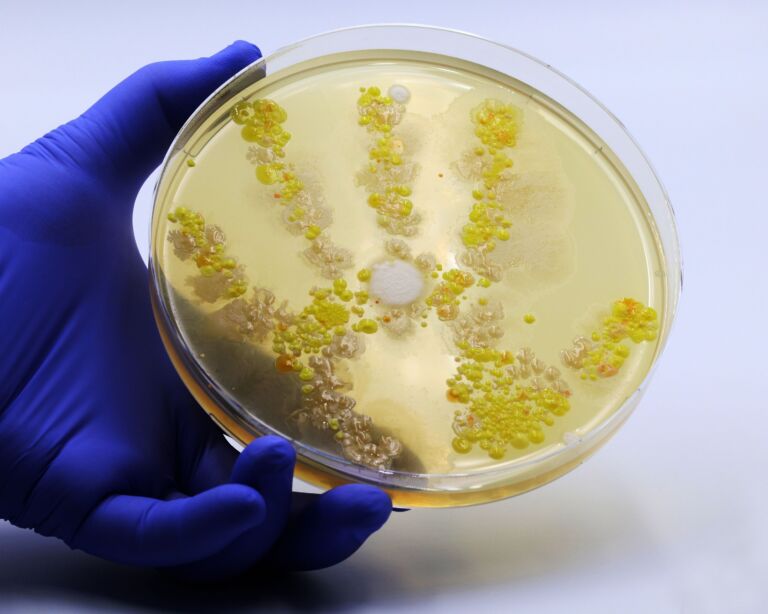
Bakterien- und Pilzkolonien in einer Schale

The cause is bacteria such as streptococci, staphylococci, pneumococci, salmonella or campylobacter. We treat bacterial infections with antibiotics. In the meantime, however, there is the problem of antibiotic resistance in many countries – then common drugs no longer work.
Bacterial infectious diseases
Bacterial infectious diseases are common worldwide. Bacteria can cause diseases in a wide variety of organs, such as the skin, the respiratory and urinary tracts, or the gastrointestinal tract. The symptoms are also based on this. They range from skin rashes, cough and cold, pain during urination to nausea, vomiting and diarrhea.

Overview: What are bacterial infectious diseases?
Bacterial infectious diseases are diseases in which bacteria are at work as triggers. For example, they enter the body via the skin, respiratory tract, urethra or through the consumption of contaminated food and drink. And it happens quickly, because bacteria are everywhere in the environment – in the air, soil, water, food, surfaces, objects or animals. They also occur in every human being. No human being is germ-free or sterile. Bacteria are single-celled organisms that can take on a wide variety of shapes, such as the appearance of a sphere, rod, branched filament or cylinder.
Not all bacteria make you sick. Experts estimate that it is only about one percent of the bacteria that put us at risk. On the contrary, most bacteria are indispensable for human health. One example is the intestinal flora, which contains countless health-promoting bacteria. They keep disease-causing germs in check so that there is a balance between “good” and “bad”. In the mouth, too, there are not only bacterial pathogens such as caries or periodontitis bacteria, but also some representatives that keep the oral flora healthy.
Bacteria can colonize almost all organs, tissues and structures, for example the skin, respiratory and urinary tracts, the gastrointestinal tract or the reproductive organs. An intact immune system fights the pathogens with various strategies and eliminates them. Sometimes, however, the body’s own defense patrol does not function sufficiently. Then the pathogens can multiply and cause bacterial infectious diseases. This leads to inflammation and – depending on the organ affected – to symptoms such as skin rashes, coughs and colds, pain when urinating, nausea, vomiting, diarrhea and fever.
Bacterial infectious diseases can be treated well. The drugs of choice are called antibiotics. They are only effective against bacteria, not against viruses. Some antibiotics also help with certain fungi and parasites. But antibiotics are not always necessary immediately. Sometimes it is enough to relieve the symptoms. However, if the bacterial infection is more severe, antibiotics can save lives, for example in the case of severe pneumonia. Blood poisoning(sepsis) can also be life-threatening. In the process, the pathogens take over and spread throughout the body via the bloodstream.
Antibiotic resistance is an increasing problem in many countries. This means that some strains of bacteria become insensitive to common antibiotics – the drugs then no longer work.
Bacterial infectious diseases – frequency and age
Bacterial infectious diseases are among the most common diseases of all. Depending on the causative agent, bacterial infections occur with varying frequency. Some examples and figures on the frequency in Switzerland:
- Pneumococci: In Switzerland, there are around 1,000 serious pneumococcal infections every year – the bacteria usually cause pneumonia, less frequently sepsis or meningitis. Children under the age of two and people over 65 are particularly affected.
- Campylobacter: The bacteria are responsible for diarrheal diseases. In Switzerland, 7,000 to 8,000 cases of Campylobacter illnesses are reported each year.
- Salmonella: These bacteria cause salmonellosis, which is widespread worldwide. In Switzerland, 1,200 and 1,500 salmonella infections are registered annually.
- Borrelia: Lyme disease is a disease in which ticks transmit the bacterium Borrelia burgdorferi to humans. The Federal Office of Public Health estimates that around 10,000 people in Switzerland contract Lyme disease each year.
Chlamydia
: These bacteria are transmitted during sex. The clinical picture is called chlamydiosis. Experts estimate that about three to ten percent of sexually active people in Switzerland are affected – 70 percent of them are women. Widespread chlamydia is found in adolescents and young women under 24 years of age. Infected men are usually somewhat older.- Legionella: In Switzerland, there are about 400 cases of Legionnaires’ disease per year.
- Enterohemorrhagic Escherichia coli (EHEC): The bacteria are found in almost all industrialized countries. In Switzerland, around 500 cases are recorded per year.
- Meningococcus: Experts count about 60 severe meningococcal infections per year in Switzerland. Children under the age of five and adolescents between the ages of 15 and 19 are particularly likely to fall ill.
In principle, bacterial infections can affect people of any age – from babies to senior citizens. If the body’s defenses are lowered, for example due to other illnesses or old age, bacteria often have an easy time of it. They enter the body, multiply and trigger inflammation.
Symptoms: Bacterial infectious diseases cause a wide variety of symptoms
The symptoms of bacterial infectious diseases always depend on which organ or organ system the bacteria attack. Thus, the symptoms differ for infections of the digestive tract, respiratory and urinary tracts, reproductive organs, skin, eyes, ears or brain. A selection of common bacterial infections and their symptoms.
Bacterial infections of the respiratory tract: symptoms
Bacteria can invade the upper (nose, throat, sinuses) or lower respiratory tract (lungs) and damage the mucous membranes there. The exact symptoms depend on the bacterium that has affected the respiratory tract. Usually, a respiratory infection can be recognized by the following symptoms:
- tiredness, fatigue, feeling of weakness
- Rhinitis – the nose runs and is stuffy
- Cough
- Difficulty breathing, shortness of breath
- Sore throat
- Headache
- Fever
Most have overcome the respiratory infection after one to two weeks and the symptoms have subsided. In the case of pronounced symptoms that do not improve or even worsen, as well as high fever, a visit to the doctor is always advisable.
Bacterial gastrointestinal infections: Symptoms
Gastrointestinal infections are among the most common infectious diseases worldwide. Many people quickly catch the germs through contaminated food and drinks. This is especially true in countries where hygiene standards are not good. Common triggers are Salmonella, Campylobacter or EHEC.
The intensity of symptoms depends on the pathogen and the state of your immune system. The following signs may indicate a gastrointestinal infection with bacteria:
- Nausea and vomiting
- Abdominal pain
- Diarrhea – this causes the body to lose a lot of fluid and electrolytes
- Bloating
- Tiredness, fatigue
- Decrease in physical performance
- Feeling of weakness
- Dizziness
- Fever
Normally, the symptoms subside within a few days and the bacterial infection heals. However, vomiting diarrhea can be extremely hard on some people, such as those with weakened immune systems, seniors, babies and young children. You should come and see us.
Bacterial infection of the skin: symptoms
Bacteria – along with fungi – are considered the most common triggers of skin infections. For example, Staphyloccocus aureus can cause nail bed inflammation and Corynebacteria can cause superficial skin inflammation.
Symptoms depend on which bacterium has invaded the skin and how large and deep the inflammation is. The following complaints and skin changes are possible with skin infections:
- Skin rash, which can look different and occur on different parts of the body: e.g. blisters filled with fluid or pus, nodules, pustules, papules, wheals, red spots – on the basis of the appearance, general practitioners can often already draw conclusions about the causative agent
- Redness of the skin
- Itching
- Pain
- Swelling of the skin
- Overheating of the skin
- The skin scales
- Boils – a deep, very painful inflammation of the hair follicle and surrounding tissue, usually caused by Staphylococcus aureus.
- Skin lichen, e.g. impetigo contagiosa – here pustules and pustules form, mainly on the face. Children are often affected. The causative bacteria are staphylococci, but also streptococci.
- Ulcers, e.g. phlegmon: defects that extend into deeper layers of the skin. Bacteria can penetrate over it and cause purulent inflammation. Sometimes the surrounding tissue takes permanent damage.
It is best to see us promptly if you have skin inflammation. In severe skin infections, the bacteria can also spread via the bloodstream – life-threatening blood poisoning(sepsis) can develop. We need to treat them immediately.
These symptoms are possible in sepsis:
- severe feeling of sickness
- High fever
- Confusion
- The skin feels hot.
- rapid breathing
- accelerated heartbeat
- pale or gray skin
Bacterial urinary tract infection: symptoms
Urinary tract infections particularly often affect women. The reason lies in the female anatomy: women have a shorter urethra than men. This makes it easier for bacteria to rise in the urinary tract and cause inflammation. Intestinal bacteria are often to blame, for example Escherichia coli.
The following symptoms indicate a urinary tract infection:
- Pain and burning during urination
- Blood in urine
- frequent urination
- frequent urination
- pronounced feeling of sickness
- sometimes fever and chills
Bacteria can also infect many other organs, such as the eyes (e.g. B. bacterial conjunctivitis), ears(middle ear infection) or the genitals (e. g. B. Chlamydia, gonorrhea, syphilis). There they cause various symptoms.
Bacterial infectious diseases: Diagnosis with us
Always see your primary care provider first if you experience symptoms. In the case of complaints of the urinary and genital organs, a USZ specialist from urology, gynecology or andrology is the right person to contact. Otherwise, the skin, eye and ear, nose and throat specialist at the USZ is the right choice. The diagnosis of a bacterial infectious disease always begins with a discussion of the patient’s medical history, the anamnesis.
We ask you some questions, for example:
- What symptoms do you experience exactly?
- Where are they located? Respiratory tract, urinary tract, reproductive organs, skin?
- How pronounced are they?
- How long have the complaints existed?
- Do you have any known diseases?
- Have you recently had contact with a person suffering from a contagious disease?
- Are you taking any medications or using any other therapies?
- Have you been traveling recently?
- Have you been in the hospital recently?
- Have you recently consumed food or beverages that may have been contaminated?
- Questions about your sex life, e.g., whether you have frequently changing sexual partners or use condoms to protect yourself during sexual intercourse
This is usually followed by a physical examination, for example of the skin or genital organs. For respiratory infections, we listen and tap the lungs. We also check the heart activity with the stethoscope.
Further diagnostic methods depend on which organ the bacterial infectious disease affects. For example, a smear test is used in which we obtain cell material. Analysis in the laboratory under the microscope usually shows which bacterium is causing the infection. The treatment is also based on this.
Bacterial infectious diseases: Prevention, early detection, prognosis
You can prevent bacterial infectious diseases by taking various measures. Vaccinations are available against some bacterial infectious diseases, such as pertussis or tetanus. The Federal Commission for Immunization Issues (EKIF) has drawn up the Swiss Vaccination Plan. You can find out more about this on the information platform for vaccination issues.
Prevent bacterial infections – Tips
The most important protection against bacteria and other pathogens is adequate hygiene. Some tips:
- Wash hands: Wash your hands regularly and thoroughly with soap and water, for example after using the toilet, blowing your nose, before preparing food or after contact with animals and waste. Dry your hands well afterwards. By washing your hands, you already eliminate most of the bacteria. The hands are considered important carriers of bacteria and other pathogens.
- Kitchen and food: Good hygiene is also important when cooking and preparing food. Consumption of contaminated food is considered the main route of transmission in diarrheal diseases. Pay attention to cleanliness in the kitchen (e.g., knives, cutting boards), refrigerate perishable foods well, heat meat sufficiently, and wash fruits and vegetables that you plan to eat raw well under running water beforehand. In countries with low hygiene standards, the phrase “peel it, boil it, cook it or forget it!” applies – in other words, peel, boil, fry or do without.
- Clean your home often and thoroughly: This applies especially to places where a lot of bacteria cavort, such as in the toilet, bathroom and kitchen.
- Cough and sneeze properly: Keep your distance from others or turn away. It is best to use a disposable handkerchief, which you dispose of immediately afterwards. If you do not have one at hand: cough or sneeze into the crook of your arm. And: Don’t forget to wash your hands afterwards.
- Protection during sex: Use condoms during sexual intercourse. For women there are femidoms. They not only protect against unwanted pregnancy, but also against pathogens of all kinds – including bacteria.
- Protection from ticks in the countryside: Wear light-colored, closed clothing with long sleeves and legs on walks and hikes. Protection is also provided by sturdy shoes and stockings that you pull over your pants.
There are no special measures for the early detection of bacterial infectious diseases in the doctor’s office. Bacterial infections are among the most common infectious diseases. Most people come into contact with these at some point in their lives. Therefore, the general recommendation is always to see us if you experience symptoms that seem unusual.
Course and prognosis in bacterial infectious diseases
The course and prognosis of bacterial infections cannot be generally predicted. They depend on various factors, such as the type of pathogen and the extent of the infection. The state of your immune system also plays an important role. Thus, small children, people with weakened immune systems, or the elderly often have a harder time defending themselves against bacteria and other invaders. An intact immune system can also cope with the bacteria itself and antibiotics are not always necessary. However, with adequate treatment, bacterial infectious diseases usually heal completely. They usually do not leave any consequential damage.